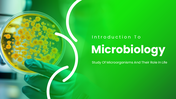
702130-introduction-to-microbiology-ppt-presentation-01

Introduction To Microbiology PPT And Google Slides
Introduction To Microbiology PowerPoint, Google Slides, and Canva Template
Make complex science simple and engaging with this clean and modern Microbiology PowerPoint Template. Designed with a fresh green color theme, this presentation helps you explain the world of microorganisms in a clear and visually attractive way.
This template covers key microbiology topics like bacteria, viruses, fungi, microbial cells, growth, and reproduction. Each slide is thoughtfully designed to help you present scientific ideas step by step, making it easy for your audience to understand—even if they are new to the subject.
It is a great choice for students, teachers, researchers, medical professionals, and science educators who want to present microbiology concepts in a structured and professional format. Whether you are teaching a class, presenting a research topic, or creating educational content, this template supports your message effectively.
With fully editable shapes, diagrams, and layouts, you can quickly customize the content, change colors, and add your own data. The clean design and visual elements make your presentation more engaging and easy to follow.
Download now biology PowerPoint template and bring microbiology concepts to life with clear and creative slides!
Features of this template
- 100% customizable slides and easy to download.
- The slides contain 16:9 and 4:3 formats.
- Easy to change the colours quickly.
- Highly compatible with PowerPoint, Google Slides, and Canva templates.